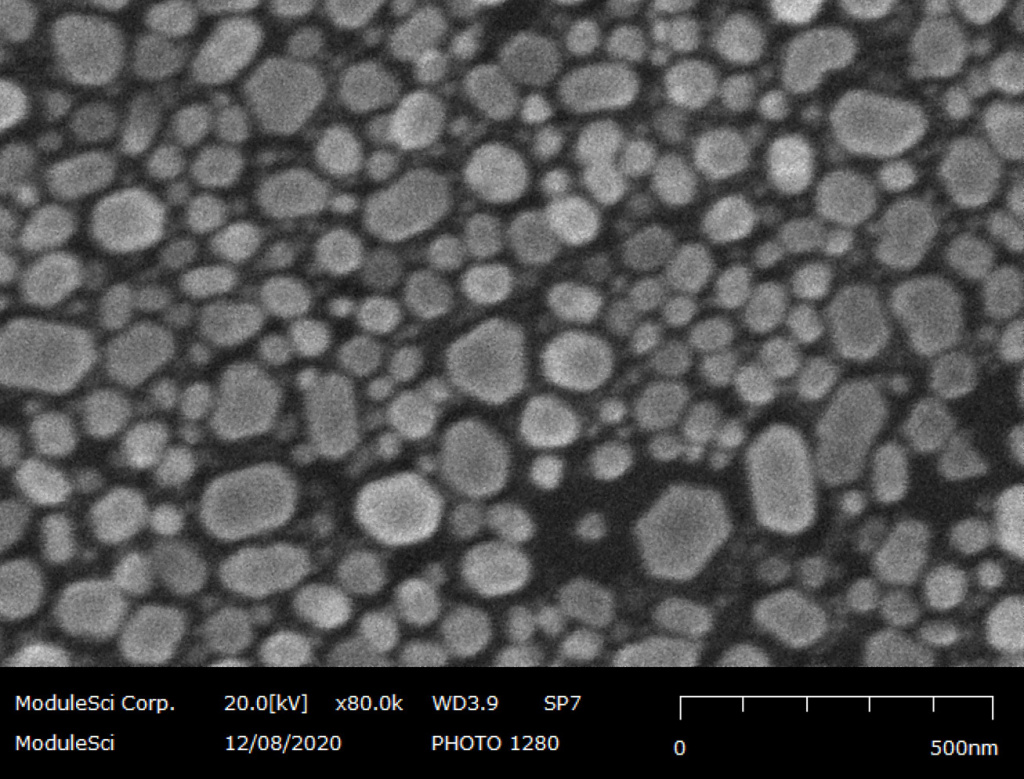
Au particle.jpg

Поиск
Компания
О компании
Политика конфиденциальности
Каталог оборудования
Комплексное оснащение рабочих мест
Комплексная электростатическая защита ✦ Продукты для контроля статического электричества и расходные материалы для защиты от электростатических разрядов
Антистатические рабочие места
Антистатические краски
Антистатические напольные покрытия
Антистатические стулья и табуреты
Антистатические коврики
Антистатическая упаковка
Измерительное и испытательное оборудование
Антистатическая спецодежда и обувь
Антистатические браслеты заземления и провода
Аксессуары для заземления
Антистатическая тара
Антистатические системы транспортировки
Свабы
Оборудование и аксессуары для уборки
Антистатические материалы для уборки и обслуживания
Антистатический скотч, предупреждающие таблички и этикетки
Антистатические щетки
Ионизаторы воздуха
Антистатический ручной инструмент
Антистатические канцелярские принадлежности
Антистатические листовые пластики и плёнки
Стандарты по антистатике и обучающие материалы
Обучение и аудит
Профессиональное паяльное оборудование
Паяльные и ремонтные станции
Оборудование для термической зачистки изоляции (термострипперы)
Подогреватели печатных плат
Дымоудаление и фильтрация паров припоя и флюсов
Роботизированная пайка
Ручная и автоматическая очистка жал паяльника
Термоинструменты и подставки
Картридж-наконечники, наконечники и сопла
Программное обеспечение для оборудования JBC
Аксессуары
Расходные материалы для пайки
Высокоточные ручные инструменты для электроники
Паяльные ванны / ванны для лужения
Оборудование для реболлинга BGA И CSP компонентов
Антистатическая мебель
Промышленная мебель
Рабочие места
Стеллажи, тележки, стенды и стойки
Мобильные основания
Роботизация радиоэлектронных производств
Роботизированная пайка
Роботизированная пайка на базе коллаборативного робота
Роботизированная пайка на базе промышленного робота
Ручной инструмент
Бокорезы, кусачки, плоскогубцы
Вакуумные пинцеты
Электрические винтовёрты
Пинцеты
Ножницы
Отвертки
Инструмент для зачистки и обжимки кабеля
Ручной инструмент для формовки выводов компонентов
Наборы инструментов
Аксессуары для рабочего места
Электроножи
Вакуумный отсос
Оборудование для дымоудаления и фильтрации воздуха
Дымоуловители Bofa
Дымоприемники Bofa
Воздуховоды Bofa
Фильтры Bofa
Переходники, струбцины для крепления, хомуты Bofa
Визуальный контроль
Системы визуального контроля
USB-микроскопы
Лампы-лупы
Сопутствующее оснащение
Светильники
Вакуумная упаковка
Вакуумные упаковочные машины
Пакеты, индикаторы влажности
Компрессоры
Безмасляные
Масляные
Системы дозирования
Дозаторы
Иголки
Аксессуары
Расходный материал для дозирования
Материалы для пайки
Паяльная паста
Припой в шариках
Флюсы
Тестовые наборы и компоненты Top Line
Тестовые компоненты
Упаковка Gel-Pak для хранения и переноса кристаллов
Контейнеры Gel-Box
Контейнеры Gel-Tray
Контейнеры Gel-Slide
Контейнеры VR с вакуумной разблокировкой
Контейнеры для пластин и подложек
Контейнеры NDT для наноустройств
Аксессуары для контейнеров с вакуумной разблокировкой
Форматные гель-пленки Gel-Film
Мембранные боксы (контейнеры)
Контейнеры Gel-Pak (коробки) без геля
Контейнеры Gel-Pak для драгоценных камней
Контейнеры Gel-Pak для ювелирных изделий
Тара для хранения полупроводниковых пластин, подложек, кристаллов, оптоэлектронных устройств и микросхем
Контейнеры (треи / лотки) Waffle Pack для хранения, защиты и транспортировки микросхем, необработанных кристаллов, CSP, оптоэлектроники и других микроэлектронных устройств: TRAPICHE, HINER-PACK
Мембранные боксы для переноски объектов неправильной или не плоской формы: CRYSPACK, GEL-PAK, LICEFA
Поддоны JEDEC (треи, лотки) для обращения, хранения и транспортировки интегральных схем, модулей и других компонентов
Тара для хранения и перевозки полупроводниковых пластин: HINER-PACK, CRYSPACK
Упаковка CrysPack для хранения и переноса кристаллов, линз и объектов неправильной формы
Стандарты и обучение
Обучающие курсы
Стандарты
Оснащение чистых помещений
Мебель для чистых помещений
Оборудование и материалы для чистых помещений
Одежда и обувь для чистых помещений
Техническая микроскопия
Безокулярные оптические микроскопы
Система презентации стереоизображений
Системы бесконтактных измерений
Цифровые системы 3D инспекции и визуального контроля
Растровые электронные микроскопы
Оптические профилометры (интерференция белого света)
Научно-исследовательские и лабораторные микроскопы
Бинокулярные стереомикроскопы
Просвечивающая электронная микроскопия
Металлографические микроскопы
Конфокальные микроскопы
Атомно-силовые микроскопы
Термоэмиссионные микроскопы
Флуоресцентные микроскопы
Интерференционные микроскопы
Профильные проекторы
Сканирующие акустические микроскопы
Рентгеновские микроскопы
Видеоэндоскопы
Портативные эндоскопы
Настольные эндоскопы
Телескопические эндоскопы
Комплектующие
Оборудование для виброзащиты
Антивибрационные платформы
Оптические столы с виброизоляцией
Оптические плиты (столешницы)
Виброизоляционные платформы для оптических столов
Виброопоры
USB-микроскопы
Комплектующие для микроскопов
Лампы-лупы
Научно-исследовательское и лабораторное оборудование
Хроматография
Хроматографы и спектрометры
Генераторы водорода и азота
Системы очистки воды
Рентгеновское аналитическое оборудование
Рентгеновская спектрометрия
Дифракция
Рентгенофлуоресцентные анализаторы покрытий (РФА толщиномеры)
Подготовка проб для РФА (XRF)
Микрорентгено-флуоресцентный анализ
Подготовка образцов
Подготовка образцов для металлографии и петрографии
Подготовка образцов для микроэлектроники
Подготовка образцов для РФА
Химическая и лазерная декапсуляция
Портативные анализаторы металлов и сплавов
Портативные лазерные анализаторы с определением углерода (LIBS)
Портативные рентгено-флуоресцентные анализаторы (XRF)
Твердомеры
Твердомеры универсальные
Нанотвердомеры
Гель-документирующие системы
Спектральное оборудование
Анализаторы кислорода, азота и водорода
Потоковые онлайн анализаторы LIBS
Анализаторы серы и углерода
Оптико-эмиссионные спектрометры
Спектрофотометры
Анализаторы частиц по размерам и элементам
Антивибрационные решения
Оборудование для механических испытаний
Электромеханические разрывные машины
Сервогидравлические разрывные машины
Экстензометры и оснастка
Технологическое оборудование
Ультразвуковой контроль
Метрологические решения
Координатно-измерительные машины
Стационарные координатно-измерительные машины
Переносные координатно-измерительные системы
Зубоизмерительные машины Liebherr WGT
Программное обеспечение
Комплектующие к координатно-измерительным машинам
Длиномеры
Измерительно-инспекционные машины
Для контроля резьбовых деталей
Промышленное контрольно-измерительное оборудование
Для контроля гладких деталей
Видеоизмерительные системы
Формоизмерительное оборудование
Профилометры
Контурографы
Кругломеры
Системы для контроля режущего инструмента
Мультисенсорные измерительные машины
Высокомеры
Измерительные микроскопы
Регистраторы температуры и влажности
Лазерные 3D-сканеры
Средства допускового контроля (калибры)
Автоматизированные системы хранения
Автоматизированные системы хранения Ferretto Group
Автоматизированные системы для хранения металла TRAFO
Автоматизированные системы со специальными условиями хранения
Стационарные стеллажи для тяжелых грузов
Специальная техника
Специальная техника для обработки длинномерных, тяжелых и негабаритных изделий
Специальная техника для перемещения грузов
Поломоечные машины
Архивное оборудование
Роботизированная техника AMR (Autonomous Mobile Robot) и AGV (Automated Guided Vehicle)
Складские роботы AGV (Automated Guided Vehicle)
Складские роботы AMR (Autonomous Mobile Robot)
WMS система управления складом
Пневматические и гидравлические комплектующие
Пневматические комплектующие
Арматурные клапаны
Пневматические приводы
Пневматические распределители
Линейные клапаны
Устройства подготовки воздуха
Соединения резьбовые
Дополнительное оборудование
Фитинги и трубки
Аксессуары
Быстроразъемные соединения
Гидравлические комплектующие
Гидравлические шестеренные насосы
Секционные клапаны HDF
Гидрораспределители и Клапаны Ду 4 (CETOP 02)
Гидрораспределители и Клапаны Ду 6 (CETOP 03)
Гидрораспределители и Клапаны Ду 10 (CETOP 05)
Гидрораспределители и Клапаны Ду 16…32 (CETOP 07-08)
ATEX
Пропорциональные клапаны
Картриджные клапаны
Линейные клапаны
Клапаны трубного монтажа
Прочие изделия
Фильтры
Теплообменники
Насосные станции
Гидроцилиндры
Направляющие распределители для мобильной техники
Гидромоторы
Гидравлические дисковые тормоза и клапаны
Гидростатические рулевые устройства
Гидравлика произведённая аддитивными методами
Лист запросов
Услуги
Комплексное оснащение рабочих мест
Неразрушающий контроль и научно-исследовательское оборудование
Метрологические решения
Автоматизированные системы хранения
База знаний
Статьи и публикации
Каталоги и брошюры
Вопросы и ответы
Личный кабинет
Личные данные
Ваше оборудование
Заявки на сервис
Анкеты
Задать вопрос
Лист запросов
Подписка
Контакты

ООО «Остек-АртТул»
121087, г. Москва, ул. Барклая, д. 6, стр. 3, эт/ком 5/1-17
(495) 788-44-44, (495) 788-44-42
www.arttool.ru, info@arttool.ru
ИНН 7731481038, КПП 773001001, ОГРН 5147746189036,
ОКПО 99721242
121087, г. Москва, ул. Барклая, д. 6, стр. 3, эт/ком 5/1-17
(495) 788-44-44, (495) 788-44-42
www.arttool.ru, info@arttool.ru
ИНН 7731481038, КПП 773001001, ОГРН 5147746189036,
ОКПО 99721242
Запросить в один клик
Заказать звонок